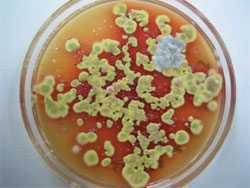
Грибок Penicillium marneffei (фото с сайта www.imperial.ac.uk)

Результаты исследования, проведенного сотрудниками Лондонского имперского колледжа, заставляют предположить, что переход биологического вида к неполовому принципу размножения ведет к утрате им эволюционных перспектив и, как следствие, к его вымиранию.
Научная работа, опубликованная в издании Public Library of Science. Pathogens, базируется на исследовании генетической структуры грибка Penicillium marneffei, размножающегося неполовым путем.
P. marneffei — дрожжеподобный грибок, вызывающий инфекции у людей с ослабленным иммунитетом, в частности у ВИЧ-инфицированных. Распространен только в Юго-Восточной Азии, в основном в Таиланде.
Несмотря на то что споры P. marneffei, несомые воздушными потоками, успешно преодолевают значительные расстояния, грибку не удается захватить ни одного мало-мальски значимого плацдарма: ареал обитания P. marneffei по-прежнему ограничен Юго-Восточной Азией, говорится в пресс-релизе Лондонского имперского колледжа.
Как полагает ведущий автор исследования доктор Мэт Фишер (Mat Fisher), неспособность P. marneffei адаптироваться к новым условиям напрямую связана с избранным им методом размножения. Отказавшись от разделения на полы, P. marneffei лишился возможности постоянного смешения генов, позволяющего отбирать наиболее подходящие для новых условий комбинации и создавать новые колонии.
С помощью анализа ДНК исследователи показали, что в разных условиях окружающей среды обитают разные клоны грибков. Причина, по-видимому, в том, что грибки, приспособленные к одним условиям жизни, не могут приспособиться к другим. При этом образцы из разных районов обитания грибка генетически оказались всё равно очень похожими. Это навело ученых на мысль, что именно высокая приспособленность грибка к конкретному региону мешает его распространению на другие ареалы.
По словам соавтора работы доктора Билла Хэниджа (Bill Hanage), бесполый грибок P. marneffei не только ограничен в своих адаптивных способностях, но даже подвержен риску полного исчезновения. Будучи не в состоянии приспособиться к условиям другой окружающей среды, он не сможет приспособиться и к изменившимся условиям среды в том регионе, где он обитает.
Таким образом, исследование, проведенное Фишером и его коллегами, подтверждает одно из положений эволюционной теории, в соответствии с которым на небольшом отрезке времени бесполые организмы вполне могут процветать и даже подавлять своих конкурентов, предпочитающих половое размножение, однако в конечном итоге их вытесняют в узкую экологическую нишу, в которой они еще способны выживать (и даже процветать), но из которой уже неспособны вырваться. В долгосрочной перспективе этот вид может оказаться тупиковой ветвью эволюции и обречен на исчезновение.



